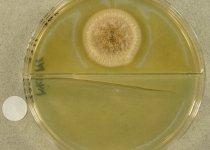

Search Details
| UAMH Number: | 929 |
|---|---|
| Species Name: | Sagenomella diversispora |
| Type: | Scopulariopsis diversispora |
| Synonyms: | Acremonium diversisporum / Paecilomyces variabilis / Sagrahamala variabilis / Scopulariopsis diversispora |
| Taxonomy: | FUNGI Ascomycota, Eurotiomycetes, Eurotiales, Trichocomaceae |
| Strain History: | Bouwens -> CBS 354.36 -> UAMH |
| Substrate: | soil under Buxus sempervirens, strain van Beyma | Location: | NETHERLANDS (GEO: 52.133,5.291) |
| Isolator: | Bouwens |
| Isolation Date: | |
| Date Received: | 1961-05-08 |
| Characters: | CYCLOHEXIMIDE sensitive (MYC) - // MESOPHILIC NG @ 35C - // MOLECULAR SYSTEMATICS relationship to Phialosimplex within the Trichocomaceae - Sigler L, Sutton DA, Gibas CF, Summerbell RC, Noel RK, Iwen PC, Med Mycol 48:335-345, 2010 // ODOR/ ODOUR fruity - (Click for publications citing UAMH 929) |
| Compounds: | |
| Cross Reference: | CBS 354.36 // IAM 14790 // MUCL 9029 |
| Collections: | Living Strains; Dried Herbarium Material |
| Pathogenic Potential: | Human: no | Animal: no | Plant: no |
| Biosafety Risk Group: | RG1 (check the PHAC ePATHogen Risk Group Database for updates) |
| Regulatory Requirements: | No restrictions for Canadian requesters. International requesters must provide all legally required importation documentation prior to shipment. Plant pathogenicity status may be verified by using the USDA Agricultural Research Service (ARS) Fungal Database |
| MycoBank ID: | 323034 |
| Sequences: | >UAMH00929_AB024589_SSU AAAGATTAAGCCATGCATGTCTAAGTATAAGCAATCTATACGGTGAAACTGCGAATGGCTCATTAAATCAGTTATCGTTTATTTGATAGTACCTTACTACATGGATACCTGTGGTAATTCTAGAGCTAATACATGCTGAAAACCTCGACTTCGGAAGGGGTGTATTTATTAGATAAAAAACCAATGCCCTTCGGGGCTCCTTGGTGATTCATAATAACTAAACGAATCGCATGGCCTTGCGCCGGCGATGGTTCATTCAAATTTCTGCCCTATCAACTTTCGATGGTAGGATAGTGGCCTACCATGGTGGCAACGGGTAACGGGGAATTAGGGTTCGATTCCGGAGAGGGAGCCTGAGAAACGGCTACCACATCCAAGGAAGGCAGCAGGCGCGCAAATTACCCAATCCCGATCCGGGGAGGTAGTGACAATAAATACTGATACAGGGCTCTTTTGGGTCTTGTAATTGGAATGGGTACAATCTAAATCCCTTAACGAGGAACAATTGGAGGGCAAGTCTGGTGGACCATCAGTTCTACAATGCTGACGCCAGAGATAGCAGGGCCCCCTCCGGGGGGTTACGCCTGCTAGTCGAGCACTCGCGATCGCGATGGGTGAGTGCCGGCGAGGTGACCTGGTACGGGGAAGCCTAAGGATCTCGGCCGCGAGGGCGGTCGGGTCTATGGTGATCCCGTGGCGAGCTGTGGGAGGGGACAGCCGTCGTAACGCGCGGAAAGGCACCGGTCGCTTTAGCGGCTCGAGGGACGTGCTGTCCCATCCGAAAGGATGCCTTCAACTGGAGCACCCATCGTGTAAAGGTTGGAGGGGGTTTACGGCCTACGTGGTCATGAACCTGGGTACTATAAACGGCCAGCAGCCGCGGTAATTCCAGCTCCAATAGCGTATATTAAAGTTGTTGCAGTTAAAAAGCTCGTAGTTGAACCTTGGGCCTGGCTGGCCGGTCCGCCTCACCGCGAGTACTGGTCCGGCTGGGCCTTTCCTTCTGGGGAACCCCATGGCCTTCACTGGCTGTGGCGGGGAACCAGGACTTTTACTGTGAAAAAATTAGAGTGTTCAAAGCAGGCCTTTGCTCGGATACATTAGCATGGAATAATAGAATAGGACGTGCGGTTCTATTTTGTTGGTTTCTAGGACCGCCGTAATGATTAATAGGGATAGTCGGGGGCGTCAGTATTCAGCTGTCAGAGGTGAAATTCTTGGATTTGCTGAAGACTAACTACTGCGAAAGCATTCGCCAAGGATGTTTTCATTAATCAGGGAACGAAAGTTAGGGGATCGAAGACGATCAGATACCGTCGTAGTCTTAACCATAAACTATGCCGACTAGGGATCGGGCGGTGTTTCTATGATGACCCGCTCGGCACCTTACGAGAAATCAAAGTTTTTGGGTTCTGGGGGGAGTATGGTCGCAAGGCTGAAACTTAAAGAAATTGACGGAAGGGCACCACAAGGCGTGGAGCCTGCGGCTTAATTTGACTCAACACGGGGAAACTCACCAGGTCCAGACAAAATAAGGATTGACAGATTGAGAGCTCTTTCTTGATCTTTTGGATGGTGGTGCATGGCCGTTCTTAGTTGGTGGAGTGATTTGTCTGCTTAATTGCGATAACGAACGAGACCTCGGCCCTTAAATAGCCCGGTTCGCGTTTGCGGACCGCTGGCTTCTTAGGGGGACTATTGGCTCAAGCCGATGGAAGTGCGCGGCAATAACAGGTCTGTGATGCCCTTAGATGTTCTGGGCCGCACGCGCGCTACACTGACAGGGCCAGCGAGTACATCACCTTGGCCGAGAGGTCTGGGTAATCTTGTTAAACCCTGTCGTGCTGGGGATAGAGCATTGCAATTATTGCTCTTCAACGAGGAATGCCTAGTAGGCACGAGTCATCAGCTCGTGCCGATTACGTCCCTGCCCTTTGTACACACCGCCCGTCGCTACTACCGATTGAATGGCTCAGTGAGGCCTTCGGACTGGCTCAGGGGGGTTGGCAACGACCGCCCAGGGCCGGAAAGTTGGTCAAACTTGGTCATTTAGAGGAAGTAAAAGTCGTAACAAGGTT >UAMH00929_GQ169318_SSU-LSU TGGATGTATAAGTCGTAACAAGGTTTCCGTAGGTGAACCTGCGGAAGGATCATTACCGAGTGAGGGTCCCTTGCGGGCCCAACCTCCCACCCGTGTTTAACTATACCGTGTTGCTTCGGCGGGCCCACTGGGGCCTGTTCCCGGTCGCCTGGGGGGGTGAAACCCCCCGGGTCCGTGCCCGCCGGAGACCCCTTGAACCCTGAGTGAATCGAGTGTCGTCTGAGTTTGAATTAAATCATTAAAACTTTCAACAACGGATCTCTTGGTTCCGGCATCGATGAAGAACGCAGCGAAATGCGATAAGTAATGTGAATTGCAGAATTCCGTGAATCATCGAATCTTTGAACGCACATTGCGCCCCCTGGCATTCCGGGGGGCATGCCTGTCCGAGCGTCATTGCTACCCTCAAGCGCGGCTTGTGTGTTGGGCGCTGTCCCCCCGGGGACAGGCCTGAAAGGCAGTGGCGGCGTCGCGTCCGGTCCTCGAGCGTATGGGGCTTTGTCACTCGCTCTGTGGGGTCCGGCCGGGGCCTGTCTACCCCAATCTTTTCTACAAGGTTGACCTCGGATCAGGTAGGGATACCCGCTGAACTTAAGCATATCAAAAGCGA |
IMAGES: